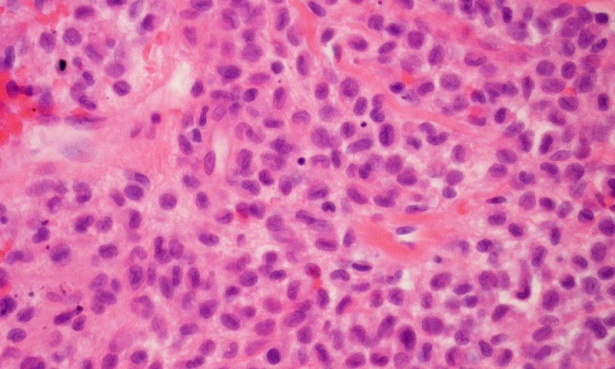

Болест на Letterer-Siwe МКБ C96.0
При болест на Letterer-Siwe се наблюдава патологична пролиферация на Лангерхансовите клетки, които са тип бели кръвни клетки.
Това е рядко срещано състояние, при което е налице инфилтрация на редица органи и структури, като кожа, лимфни възли, черен дроб, слезка, кости, бели дробове от патологично разрасналите Лангерхансови клетки. Заболяването се асоциира с хистиоцитоза на Лангерхансовите клетки и засяга най-често детската и младата възраст.
Бялата раса е по-склонна към развитие на тази неоплазия, като мъжкият пол е два пъти по-често засегнат в сравнение с женския.
Причините, провокиращи изявата на това състояние, не са напълно изяснени, но като рискови се обсъждат факторите:
- генетична предиспозиция
- вроден или придобит имунен дефицит
- малигнени хемопатии
- инфекции, например с човешкия херпесен вирус 6
- радиация
- вредни и токсични агенти от околната среда
- пренатална експозиция на някои лекарства и вредни фактори
При голяма част от пациентите болестта се представя с анемия, генерализиран кожен обрив и хепатоспленомегалия.
Анемията и намаленият брой еритроцити и хемоглобин е причина за постоянната умора и слабост при болните, бледност на кожата и видимите лигавици, наличието на диспнея. Генерализираният обрив по кожата се представя като жълтеникаво-кафеви макулопапуларни лезии, хеморагични петна и болезнена ерозия на кожните гънки. Увеличените слезка и черен дроб причиняват тежест, дискомфорт и болка в абдоминалната зона.
Често се наблюдават фебрилитет, намален апетит и анорексия, общо неразположение. При много пациенти се наблюдават чести хронични инфекции и засягане на зъбите и венците, често под формата на възпаление и некроза на венците и падане на зъбите.
Намаленият брой на тромбоцити в кръвта води до нарушения в коагулацията и значително повишава риска от кървене.
За поставяне на диагнозата е необходим обстоен клиничен преглед, лабораторни изследвания на редица показатели и образни изследвания.
При прегледа се установяват характерните кожни изменения, палпират се увеличените черен дроб и слезка и се наблюдават признаците на анемия. Тези симптоми могат да се дължат на много инфекциозни и злокачествени заболявания, затова е необходимо провеждането на допълнителни изследвания.
Пълната кръвна картина с диференциално броене, броят на ретикулоцитите, стойностите на СУЕ, директния и индиректния тест на Coombs и нивата на имуноглобулините са много показателни. Необходимо е определяне и на коагулационния статус, посредством измерване стойностите на протромбиновото време и парциалното активирано тромбопластиново време.
Изключително важно е определянето на чернодробната функция, чрез изследване на общия белтък, албумина и чернодробните ензими. При засягане на черния дроб е необходимо да се извърши и биопсия, за разграничаване от цироза. Поради високата честота на инфилтриране на вътрешните органи, е необходимо провеждане и на образни изследвания, като рентгенография, КТ, ЯМР, флуородеоксиглюкозна позитронно емисионна томография.
За потвърждение на диагнозата е необходимо извършване на биопсия на костен мозък, особено полезна е и биопсията от засегнат кожен участък.
При изготвяне на диференциалната диагноза е необходимо да се имат предвид токсична неонатална еритема, мастоцитоза, себореен дерматит, неонатална варицела, левкемия, лимфом, миелом, дисеминиран ксантом и други.
Лечението на болест на Letterer-Siwe е предимно комплексно и се състои в химиотерапия, в интензифициран режим и високи дози, поддържащо лечение със симптоматични средства.
При млади пациенти, отговарящи на определени критерии, добри резултати се постигат и след извършване на автоложна трансплантация на стволови клетки.
Заглавно изображение: fishhawk, CC BY 2.0, via Wikimedia Commons
Коментари към Болест на Letterer-Siwe МКБ C96.0